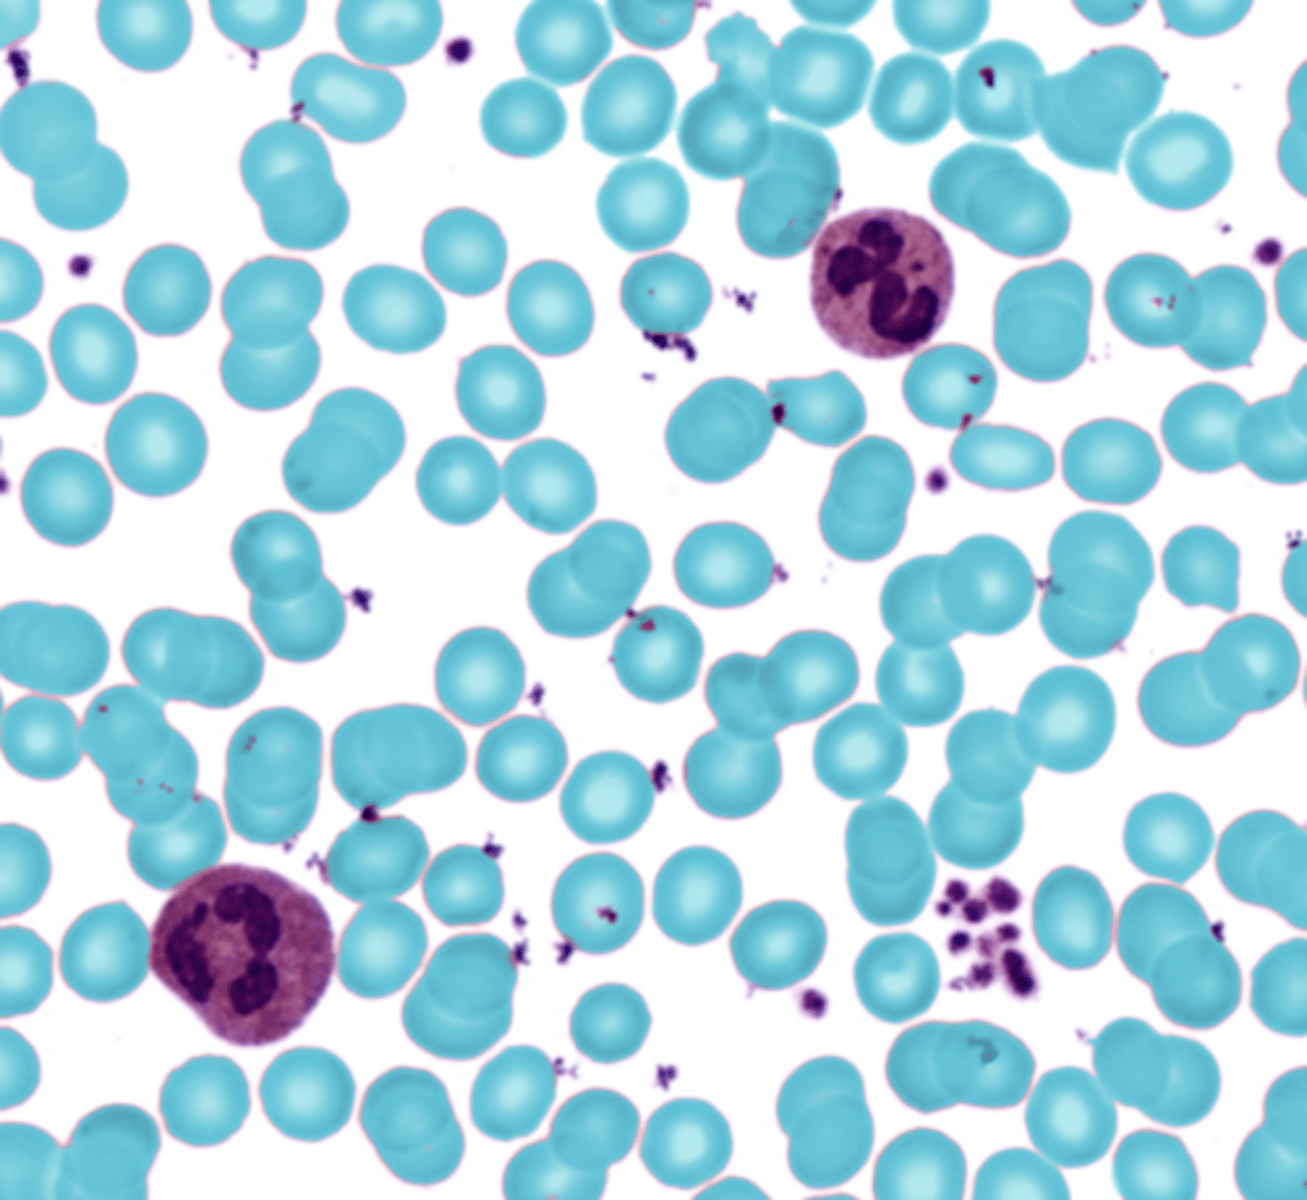
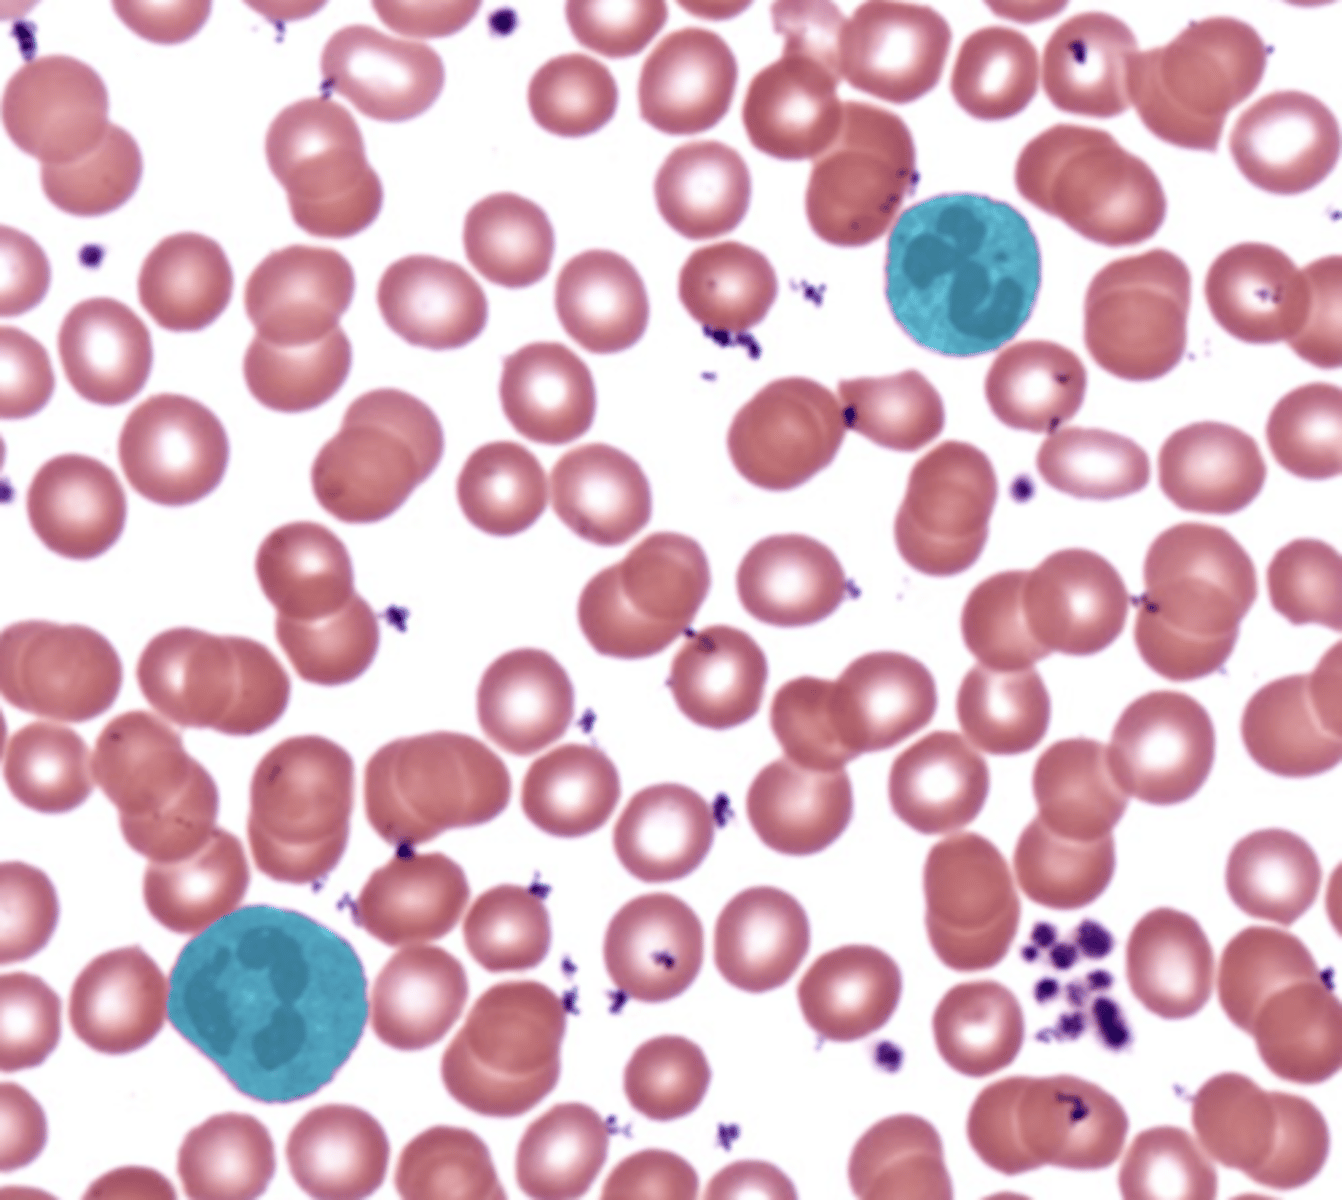
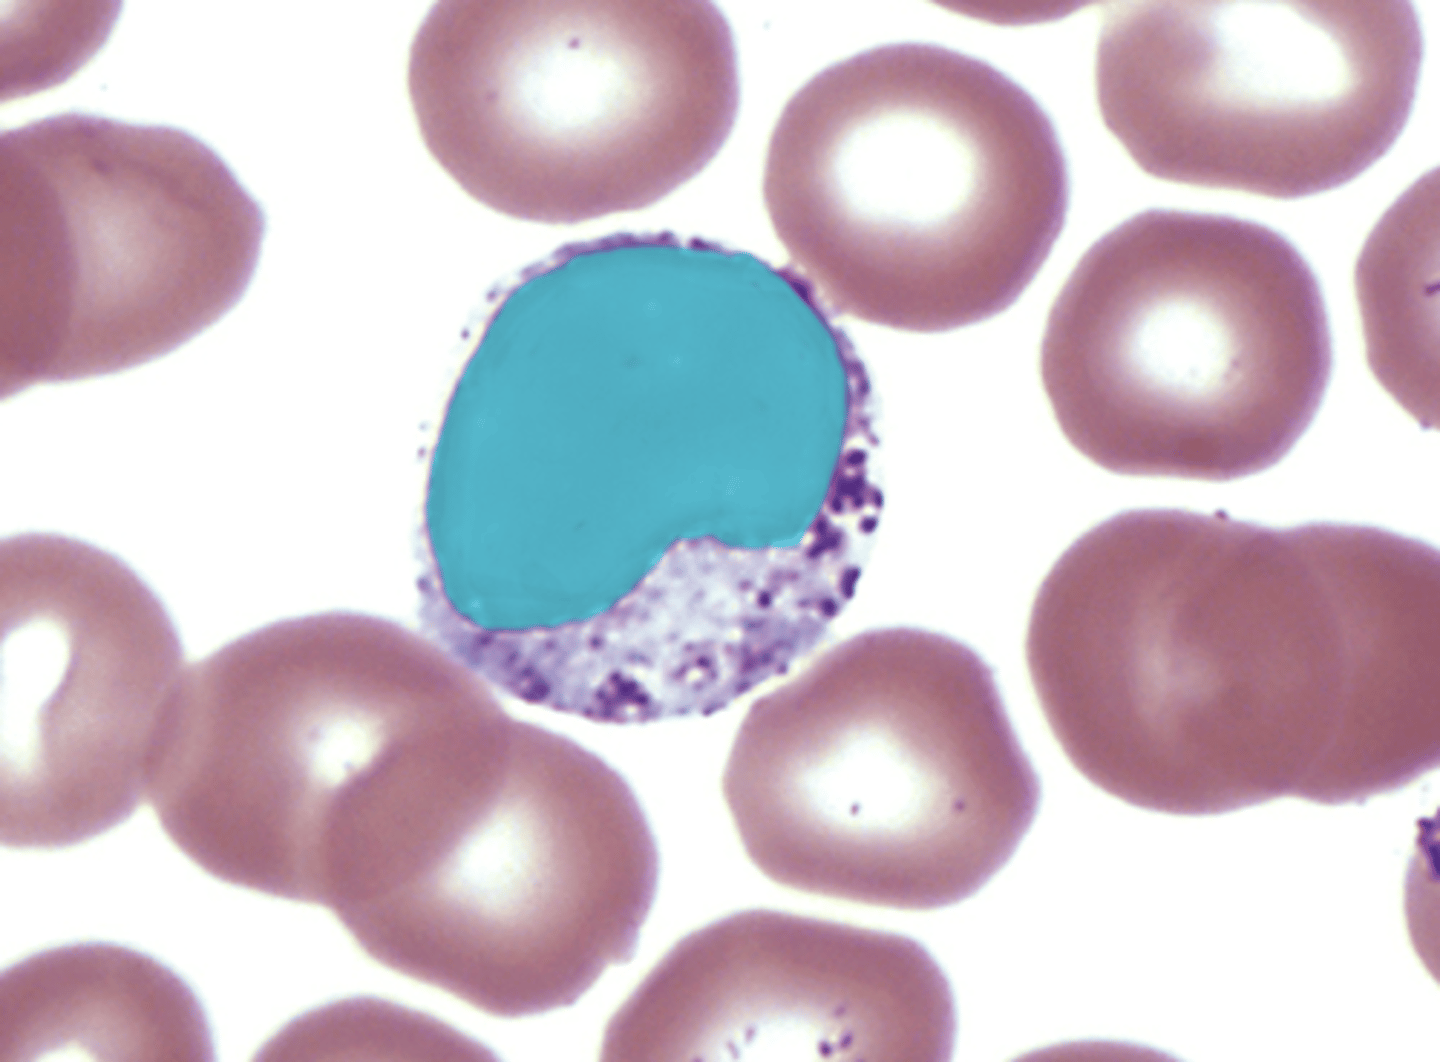
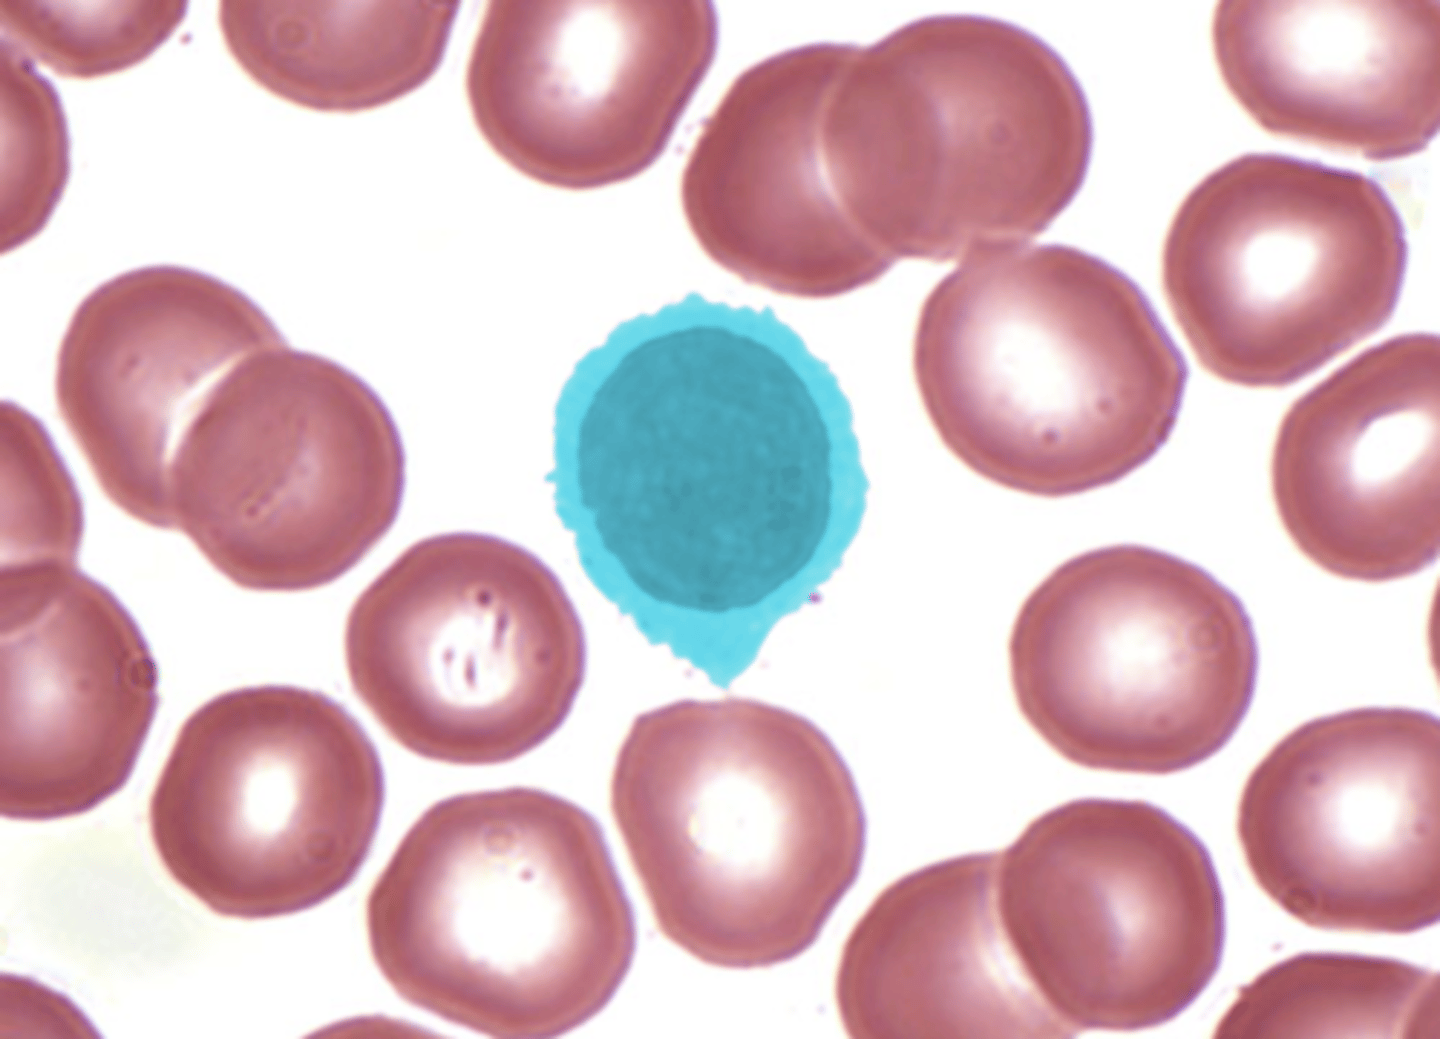

1/93
Looks like no tags are added yet.
Name | Mastery | Learn | Test | Matching | Spaced | Call with Kai |
|---|
No analytics yet
Send a link to your students to track their progress
Left atrium

Left ventricle

Right atrium

right ventricle

Apex of heart

Base of heart
purple

Chordae tendineae

Papillary muscle

interventricular septum

Aorta

Inferior vena cava

Superior vena cava

Pulmonary trunk (as distinct structure from pulm. a.)

Pulmonary artery (identify left vs. right)

Pulmonary veins (there are 4, identify left vs. right)
(pink & green)

Coronary sinus

Great cardiac vein

Circumflex branch of left coronary artery

Right coronary artery
red

Right atrioventricular valve (or tricuspid valve)

Left atrioventricular valve (or bicuspid valve or mitral valve)

Aortic valve (aortic semilunar valve)

Pulmonary valve (pulmonary semilunar valve)

Pulmonary trunk

Pulmonary artery
How does the myocardium of the left ventricle compare to that of the right ventricle?
You should know the difference between "pulmonary circulation" vs. "systemic circulation"
You should be able to identify the prior or next structure as blood circulates and/or what valve it passes through
Pulmonary vs. Systemic Circulation
Valves or structures that the blood passes through in order
A, B, Rh
What are the antigens that determine blood type?
on the surface of red blood cells
Where are the antigens located?
plasma
Where are the antibodies located?
agglutination
Clumping of red blood cells is called?
Reading blood type
Clumps with Anti-A = A antigen present.
Clumps with Anti-B = B antigen present.
Clumps with Anti-D = Rh positive.
Example 1:
Anti-A: clumps
Anti-B: no clumps
Anti-D: clumps→ Blood type A+
Example 2:
Anti-A: no clumps
Anti-B: clumps
Anti-D: no clumps→ Blood type B−
Example 3:
Anti-A: clumps
Anti-B: clumps
Anti-D: clumps→ Blood type AB+
Example 4:
Anti-A: no clumps
Anti-B: no clumps
Anti-D: no clumps→ Blood type O−
erythrocyte
- no nucleus
- Biconcave disc shape
basophil
- bilobed nucleus, U/S shaped
- blue/black granules

eosinophil
- Bilobed nucleus
- deep pink granules

neutrophil
- Leukocyte
- Multilobed nucleus
- Pale pink granules
monocyte
- large, horseshoe nucleus
lymphocyte
- round or indented nucleus
neutrophils, eosinophils, basophils
granulocytes
lymphocytes and monocytes
agranulocytes
What is the general difference between a granulocyte and agranulocyte?
Pharyngeal tonsil

Lingual tonsil

Palatine tonsil

Spleen
Axillary lymph nodes

Mediastinal lymph nodes

Peyer's patch (ileum)

Hypothalamus
Pituitary gland

Thyroid gland

Suprarenal gland

Pancreas

Testes

Ovaries

Lymphatic system: lymph nodes, spleen, thymus, tonsils, lymphatic vessels.Endocrine system: pituitary, thyroid, parathyroids, adrenal glands, pancreas, pineal gland, ovaries/testes.
Which organs/structures belong to the lymphatic system? Which to the endocrine system?
What bone protects the pituitary gland (name the specific bone in the skull)? What part of that bone specifically
(name the landmark)?
What is another name for the suprarenal gland?
What type of fluid do lymph nodes monitor/filter? (what is it called?)
What type of fluid does the spleen monitor/filter? (what is it called?)
Where is the special name for lymph nodes of the ileum called?
Where are the axillary lymph nodes located?
Anterior cerebral a. and branches
Posterior cerebral a. and branches
Basilar a.

Vertebral a.

Common carotid a. (state L or R)

External carotid a. (state L or R)

Internal carotid a. (state L or R)

External jugular v. (state L or R)

Internal jugular v. (state L or R)

Axillary a

Axillary v.

Brachial a.

Brachial vv.

Radial a.

Radial v

Ulnar a.

Femoral a.

Femoral v.

Great saphenous v.

Aorta (aortic arch)

Abdominal aorta

Brachiocephalic trunk

Left common carotid a.
Left subclavian a.
Renal a. (state L or R)

Renal v. (state L or R)

For elastic artery and vein - identify tunica externa; tunica media; tunica intima on histological images
What are the general differences between the structure of an artery and vein?
What are the three main arteries that branch off the aortic arch?